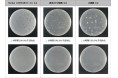

“交わる”をコンセプトに新本社へ 本社機能をワンフロアに集約
 大日本塗料
大日本塗料 大日本塗料
大日本塗料 カコムス株式会社
カコムス株式会社 一般社団法人 日本建築材料協会
一般社団法人 日本建築材料協会 大日本塗料
大日本塗料 TOPPANホールディングス株式会社
TOPPANホールディングス株式会社 TISインテックグループ
TISインテックグループ 大日本塗料
大日本塗料 大日本塗料
大日本塗料 大日本塗料
大日本塗料 大日本塗料
大日本塗料 シンロイヒ株式会社
シンロイヒ株式会社 大日本塗料
大日本塗料 ストックマーク
ストックマーク シンロイヒ株式会社
シンロイヒ株式会社 TOPPANホールディングス株式会社
TOPPANホールディングス株式会社 トヨタPR事務局
トヨタPR事務局 TOPPANホールディングス株式会社
TOPPANホールディングス株式会社 株式会社モリエン
株式会社モリエン TOPPANホールディングス株式会社
TOPPANホールディングス株式会社 三菱重工業株式会社
三菱重工業株式会社 Sansan株式会社
Sansan株式会社 三菱重工業株式会社
三菱重工業株式会社 関西ペイント株式会社
関西ペイント株式会社 大日本塗料
大日本塗料 AndTech
AndTech FCR株式会社
FCR株式会社 大日本塗料
大日本塗料 大日本塗料
大日本塗料 大日本塗料
大日本塗料 アペルザ
アペルザ